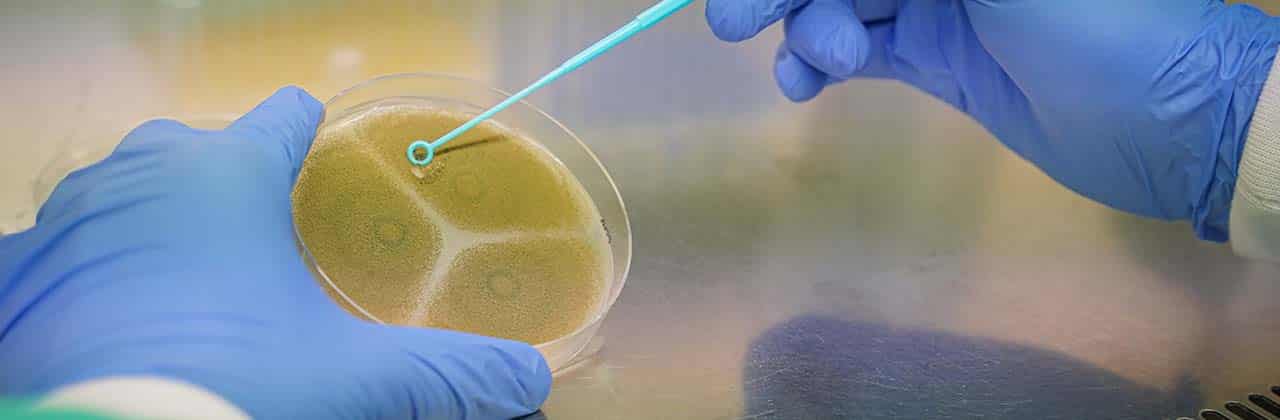

Suscríbete a nuestra newsletter
- Líneas I+D+i
- Servicios Tecnológicos
- Servicios Consultoría
- Servicios Laboratorio
- Formación y Eventos
- Sectores
Objetivo
El proyecto ANAEROBANK tiene como objetivo proporcionar a las empresas de la Comunitat Valenciana nuevos recursos biológicos para obtener alimentos funcionales y con un mejor perfil nutricional. Por otro lado, también se aportarán recursos biológicos con capacidades fermentativas con la capacidad de determinar nuevos potenciales sobre matrices alimentarias de las empresas colaboradoras. Por ello, se cuenta con la presencia de perfiles de diversa índole.
Actividades
Difusión/Transferencia:
Notas de prensa
AINIA impulsa 11 nuevos proyectos de I+D+i con el respaldo de IVACE-FEDER
| Responsable | AINIA |
| Domicilio | Calle Benjamín Franklin, 5 a 11, CP 46980 Paterna (Valencia) |
| Finalidad | Atender, registrar y contactarle para resolver la solicitud que nos realice mediante este formulario de contacto |
| Legitimación | Sus datos serán tratados solo con su consentimiento, al marcar la casilla mostrada en este formulario |
| Destinatarios | Sus datos no serán cedidos a terceros |
| Derechos | Tiene derecho a solicitarnos acceder a sus datos, corregirlos o eliminarlos, también puede solicitarnos limitar su tratamiento, oponerse a ello y a la portabilidad de sus datos, dirigiéndose a nuestra dirección postal o a [email protected] |
| Más info | Dispone de más información en nuestra Política de Privacidad |
| DPD | Si tiene dudas sobre como trataremos sus datos o quiere trasladar alguna sugerencia o queja, contacte al Delegado de protección de datos en [email protected] o en el Formulario de atención al interesado |
Consiento el uso de mis datos personales para que atiendan mi solicitud, según lo establecido en su Política de Privacidad.
Consiento el uso de mis datos para recibir información y publicidad de su entidad.